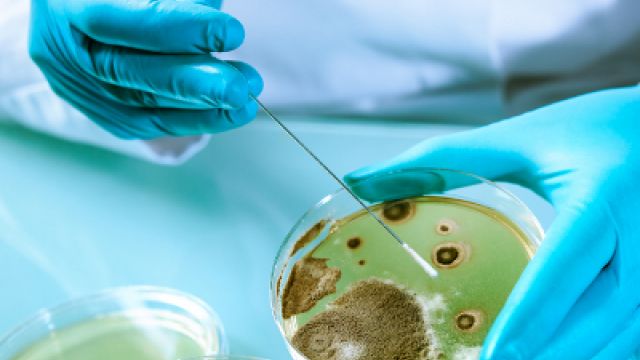
Инфекционисти предупреждават че антибиотиците не помагатЗатоплянето на времето сменя грипа

... билки, особено ако вече имате здравословни оплаквания.Важно: Ментата не е заместител на медицинско лечение. Тя е допълнение към здравословния начин на живот и балансираното хранене.
Стомаха Червата - Новини
Ароматно ободряващо и неизменна част от сутрешния ритуал – кафето
...... които кафето е изкуство и ритуал – това е добра новина. Защото няма нищо по-лошо от това да ти се пие кафе... и да не можеш.
Между десет и петнадесет пъти на денонощие е нормално човек
...... обуславя това натрупване на газове и респективно - по – честото освобождаване на голямо количество газове под формата на флатуленция", каза д-р Костадинова пред zdrave.to.
За сериозно увеличение на случаите на заболели със стомашно чревни инфекции
...... е по-голяма. Освен това трябва повишено внимание при консумацията на яйца, месо и други храни с цел избягване на хранителни натравяния”, каза още д-р Попов.
Инфекционисти предупреждават че антибиотиците не помагатЗатоплянето на времето сменя грипа
...... кабинетите на пулмолозите обаче е пълно с чакащи. Голяма част от хората са с остатъчна кашлица от вирусни заболявания, но факт вече са първите алергии.
На всеки се е случвало по време на празниците Не
...... червата. Стремете се да изпивате по една чаша вода преди всяко хранене и се опитвайте да редувате вода и празнични напитки колкото е възможно по-често.
Лекарите бяха смаяни когато откриха че жена страдаща от болки
...... на света, завеждайки детето у дома, за да се срещне с другите си две деца, които нямаха търпение да срещнат новото си братче и сестриче.
Подуването на стомаха и къркоренето на червата са често срещани
...... се препоръчва консумацията на продукти, богати на витамини В6 и Е и на магнезий и пълното отказване от кафе, захар и сол през тези дни.
Почистване на стомаха и червата Ако следвате тези съвети постоянно
...... по-сериозни здравословни проблеми. Вижте още: Домашният ви любимец може да разпознае лошия човек За почистване на стомаха и добре работеща храносмилателна система, следвайте съветите по-горе!
Комбинацията от ежедневен динамичен стрес и лошо хранене има пагубно
...... газове -Отпуска мускулите на червата, улеснява преминаването на газовете и облекчава болките в корема -Има отлично противодействие при затруднено храносмилане, гадене и повръщане -Благоприятства изхождането
Това упражнение е изключително ефективно при отстраняването на газове от стомаха
...... и червата. Магически ще се спасите от запека и стомашното разстройство. Преди да започнете упражненията, тялото и умът трябва да бъдат спокойни. Какво представлява упражнението, четете в zdrave.to
Запекът е симптом а не заболяване Докато повечето от причините са
...... или друго ястие със сусам. Една супена лъжица сусам съдържа около 1,1 грам фибри, които са ефикасни при запек. Друг добър избор са тиквените семки.
Запекът е симптом а не заболяване Докато повечето от причините са
...... или друго ястие със сусам. Една супена лъжица сусам съдържа около 1,1 грам фибри, които са ефикасни при запек. Друг добър избор са тиквените семки.